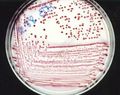

معرض الملفات الجديدة
اذهب إلى التنقل
اذهب إلى البحث
هذه الصفحة الخاصة تعرض آخر الملفات المرفوعة.
- 1280px-Progesterone during menstrual cycle.png كنان الطرح
12:56، 27 سبتمبر 2017
1٬280 × 570؛ 194 كيلوبايت
- Hybridoma cells grown in tissue culture.jpg حنان الجمال
00:58، 19 مايو 2016
1٬648 × 1٬692؛ 230 كيلوبايت